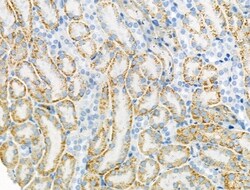
Invitrogen&trade;&nbsp;Connexin 45 Polyclonal Antibody

missing translation for 'onlineSavingsMsg'
Learn More
Learn More
Invitrogen™ Connexin 45 Polyclonal Antibody
Rabbit Polyclonal Antibody
Supplier: Invitrogen™ PA599394
Description
Antibody detects endogenous levels of total Connexin 45 / GJA7.
Gap junctions were first characterized by electron microscopy as regionally specialized structures on plasma membranes of contacting adherent cells. These structures were shown to consist of cell-to-cell closely packed transmembrane channels. Proteins, called connexins, purified from fractions of enriched gap junctions from different tissues differ. Connexins are designated by their molecular mass. Another system of nomenclature divides gap junction proteins into 2 categories, alpha and beta, according to sequence similarities at the nucleotide and amino acid levels. For example, CX43 is designated alpha-1 gap junction protein, whereas CX32 and CX26 are called beta-1 and beta-2 gap junction proteins, respectively. This nomenclature emphasizes that CX32 and CX26 are more homologous to each other than either of them is to CX43. Connexins have four transmembrane, three intracellular, and two extracellular regions. Different tissues express different connexins, though tissue specificities overlap, and a given tissue or cell can express several different connexins. Developmental regulation of at least some of the connexin genes has been found. Embryo implantation is regulated in part by temporally changing patterns of expression of connexins in the embryo and the maternal decidua.Specifications
| Connexin 45 | |
| Polyclonal | |
| Unconjugated | |
| GJC1 | |
| C130009G16Rik; Cnx45; connexin 45; connexin-45; CTC-296K1.4; CX45; Cxn-45; Gap junction alpha-7 protein; gap junction channel protein connexin 45; gap junction gamma-1 protein; gap junction membrane channel protein alpha 7; gap junction protein gamma 1; gap junction protein, gamma 1; gap junction protein, gamma 1, 45kDa; Gja7; Gja-7; GJC1 | |
| Rabbit | |
| Affinity chromatography | |
| RUO | |
| 10052, 14615, 266706 | |
| -20°C | |
| Liquid |
| Immunohistochemistry (Paraffin), Western Blot, Immunocytochemistry | |
| 1 mg/mL | |
| PBS with 50% glycerol and 0.02% sodium azide; pH 7.4 | |
| A4GG66, P28229, P36383 | |
| GJC1 | |
| A synthesized peptide derived from human GJC1(Accession P36383), corresponding to amino acid residues E341-K391. | |
| 100 μL | |
| Primary | |
| Human, Mouse, Rat, Monkey | |
| Antibody | |
| IgG |